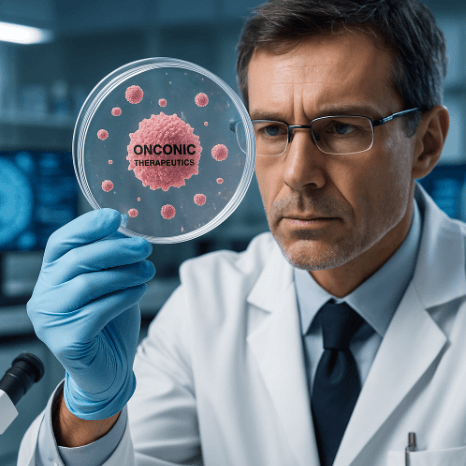

※ 투자의 책임은 본인에게 있으며 권유하는 글이 아닙니다.

1. 온코닉테라퓨틱스 기업 개요
1.1 기업 개요 및 핵심 사업
온코닉테라퓨틱스는 신약 개발 중심의 바이오 헬스케어 기업으로, 특히 항암제 분야에서 혁신적인 파이프라인을 보유하고 있는 신흥 제약 벤처입니다. 대표 파이프라인 중 하나인 ‘네수파립(Nesuparib)’은 PARP(폴리 ADP-리보스 폴리머라제) 억제제 기반의 표적 항암 치료제로, 최근 미국 AACR(미국암학회)에서 위암세포에 대한 항종양 효과를 입증한 연구 초록이 공개되어 업계의 주목을 받고 있습니다.
2. 온코닉테라퓨틱스 주가 현황
2.1 최근 주가 동향
- 종가: 19,980원 (2025년 4월 1일 기준)
- 전일 대비: +2,270원 (+12.82%)
- 52주 최고/최저: 26,100원 / 12,550원
- 거래량: 13,759,700주
- 시가총액: 약 2,174억 원


2.2 주가 상승 요인
- 美AACR에서 항종양 효과 입증 초록 발표
- 신약 개발에 대한 시장 기대감 확대
- 유망 항암 파이프라인 보유


3. 주요 투자 지표

4. 기업 실적 분석
4.1 연간 실적 분석
- 매출총이익률은 2020년부터 지속적으로 100% 유지되어, 기술수출 또는 라이선스 기반 수익 구조를 추정할 수 있습니다.
- 2023년 영업이익률은 -32.33%, 순이익률은 -54.54%로 적자 지속.
- ROE -44.55%, ROA -21.35% 등 수익성 지표는 다소 부진.
- 그러나 R&D 성격이 강한 기업 특성상, 적자는 초기 단계에서 흔한 흐름으로 판단됩니다.

4.2 분기별 실적 분석(2024년 기준 예상 포함)
- 영업이익률은 1분기 -29.19%에서 3분기 15.46%까지 반등 예상.
- 순이익률도 하반기 개선세 예상(3분기 63.70%).
- EBITDA마진율 3분기 36.34%로 높아지며 수익 구조 개선 기대감 존재.
5. 온코닉테라퓨틱스 투자 포인트
- 항암 파이프라인 ‘네수파립’ 글로벌 시장 가능성
- 美 AACR를 통한 과학적 신뢰도 확보
- 기술 이전 또는 임상 성공 시 큰 폭의 기업가치 상승 여력
- 적자 구조 개선 조짐 (EBITDA 마진율 개선)
6. 온코닉테라퓨틱스 최근 이슈
- 2025년 3월 말: 미국암학회(AACR)에서 ‘네수파립’의 위암세포 대상 항종양 효과 입증 초록 발표
- 국내외 제약·바이오 업계의 관심 집중
7. 리스크요인 분석
- 주요 파이프라인의 임상 실패 또는 지연 가능성
- 적자 구조가 장기화될 경우 투자 매력도 저하
- 기술이전 계약 부재 시 수익 모델 불확실
8. 목표주가 및 종합 주가 전망
8.1 증권사별 목표주가 현황
- 바이오 업종의 특성상 임상 성과 및 기술 수출 여부에 따라 주가가 급등락할 수 있음
- 2025년 하반기 중 글로벌 제약사와의 협업, 기술이전이 가시화된다면 목표주가 25,000원~30,000원대 형성 가능

9. 자주 묻는 질문 (FAQ)
Q1. 온코닉테라퓨틱스는 어떤 기업인가요?
- 항암 신약 개발에 주력하는 바이오 기업으로, 현재 ‘네수파립’이라는 PARP 저해제 기반의 치료제 개발에 집중하고 있습니다.
Q2. 온코닉테라퓨틱스 주가 전망은?
- 최근 AACR 발표로 긍정적 이슈가 형성되었으며, 향후 기술이전 계약이 체결될 경우 추가 상승 여력 있음.
[위 내용은 투자 권유를 위한 글이 아니며, 투자 결과에 대한 책임은 투자자 본인에게 있습니다.]
함께 보면 좋은글
2025.03.27 - [반찬값 벌려다 생활비버는 주식] - 인디에프 주가 전망 실적 이재명 '선거법 2심' 무죄 선고 남북경협 테마 상승
'반찬값 벌려다 생활비버는 주식' 카테고리의 다른 글
| 형지글로벌 주가 전망 실적 목표주가 이재명 테마주 (1) | 2025.04.04 |
|---|---|
| 이스타코 주가 전망 실적 목표주가 이재명 대표 관련 테마주 (1) | 2025.04.03 |
| 효성오앤비 주가 전망 실적 목표주가 산불 피해 복구 사업 확대 기대감 (0) | 2025.03.31 |
| 인디에프 주가 전망 실적 이재명 '선거법 2심' 무죄 선고 남북경협 테마 상승 (0) | 2025.03.27 |
| 티엘비 주가 전망 실적 목표주가 엔비디아 ‘소캠’ 공식 발표로 관련 기술 보유 (1) | 2025.03.24 |
댓글